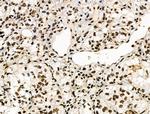
Phospho-POLR2A (Ser1616) Antibody in Immunohistochemistry (Paraffin) (IHC (P))
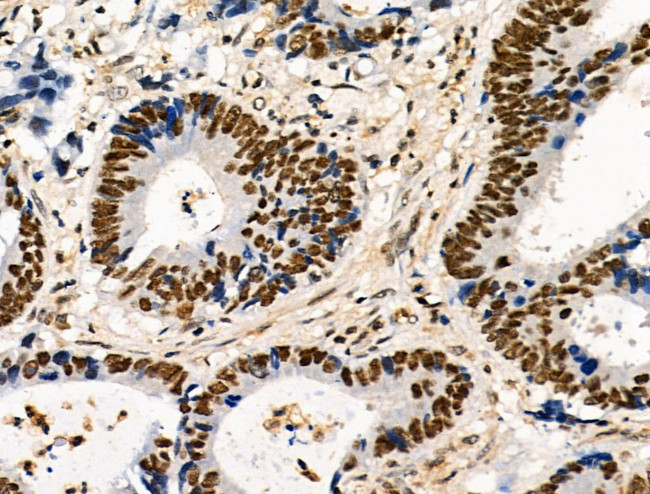
Phospho-POLR2A (Ser1616) Antibody in Immunohistochemistry (Paraffin) (IHC (P))

Search
Invitrogen
Phospho-POLR2A (Ser1616) Polyclonal Antibody
{{$productOrderCtrl.translations['antibody.pdp.commerceCard.promotion.promotions']}}
{{$productOrderCtrl.translations['antibody.pdp.commerceCard.promotion.viewpromo']}}
{{$productOrderCtrl.translations['antibody.pdp.commerceCard.promotion.promocode']}}: {{promo.promoCode}} {{promo.promoTitle}} {{promo.promoDescription}}. {{$productOrderCtrl.translations['antibody.pdp.commerceCard.promotion.learnmore']}}
图: 1 / 26
Phospho-POLR2A (Ser1616) Antibody (PA5-106067) in IHC (P)

Please note: We are reviewing Western blot images included in the antibody testing data in our catalog, including those provided by third parties. Unless expressly labeled or annotated as “raw-unedited”, Western blot images included in the antibody testing data in our catalog may have been edited, optimized or otherwise adjusted for presentation.
产品信息
PA5-106067
种属反应
宿主/亚型
分类
类型
抗原
偶联物
形式
浓度
规格
纯化类型
保存液
内含物
保存条件
运输条件
RRID
产品详细信息
Antibody detects endogenous levels of POLR2A only when phosphorylated at Ser1616.
靶标信息
DNA-directed RNA polymerase II subunit RPB1 (POLR1A) is a DNA-dependent RNA polymerase that catalyzes the transcription of DNA into RNA using the four ribonucleoside triphosphates as substrates. POLR1A is the largest subunit and is a catalytic component of RNA polymerase II which synthesizes mRNA precurors and many functional non-coding RNAs. It also forms the polymerase active center together with the second largest subunit. Pol II is the central component of the basal RNA polymerase II transcription machinery. It is composed of mobile elements that move relative to each other. RPB1 is part of the core element with the central large cleft, the clamp element that moves to open and close the cleft, and the jaws that are though to grab the incoming DNA template. At the start of transcription, a single-stranded DNA template strand of the promoter is positioned within the central active site cleft of Pol II. A bridging helix emanates from RPB1 and crosses the cleft near the catalytic stie and is through to promote translocation of Pol II by acting as a ratchet that moves the RNA-DNA hybrid through the active site by switching from straight to bent conformations at each step of nucleotide addition. During transcription elongation, Pol II moves on the template as the transcript elongates. Elongation is influenced by the phosphorylation status of the C-terminal domain (CTD) of Pol II's largest subunit (RPB1), which serves as a platform for assembly of factors that regulate transcription initiation, elongation, termination, and mRNA processing. Regulation of gene expression levels depends on the balance between methylation and acetylation levelts of the CTD-lysines.
仅用于科研。不用于诊断过程。未经明确授权不得转售。
篇参考文献 (0)
生物信息学
蛋白别名: 3'-5' exoribonuclease; DNA-directed RNA polymerase II subunit A; DNA-directed RNA polymerase II subunit RPB1; DNA-directed RNA polymerase III largest subunit; EC 2.7.7.6; MGC75453; Pol II S2p; Polymerase (RNA II (DNA directed), large polypeptide; polymerase (RNA) II (DNA directed) polypeptide A; polymerase (RNA) II (DNA directed) polypeptide A, 220kDa; POLYMERASE II; RNA; RNA POL2; RNA polymerase II 1; RNA polymerase II subunit B1; RNA-directed RNA polymerase II subunit RPB1; RP02; RPB220; RPO21; SUA8
基因别名: 220kDa; POLR2; POLR2A; Rpb1; Rpii215; Rpo2-1
UniProt ID: (Mouse) P08775
Entrez Gene ID: (Mouse) 20020, (Rat) 363633